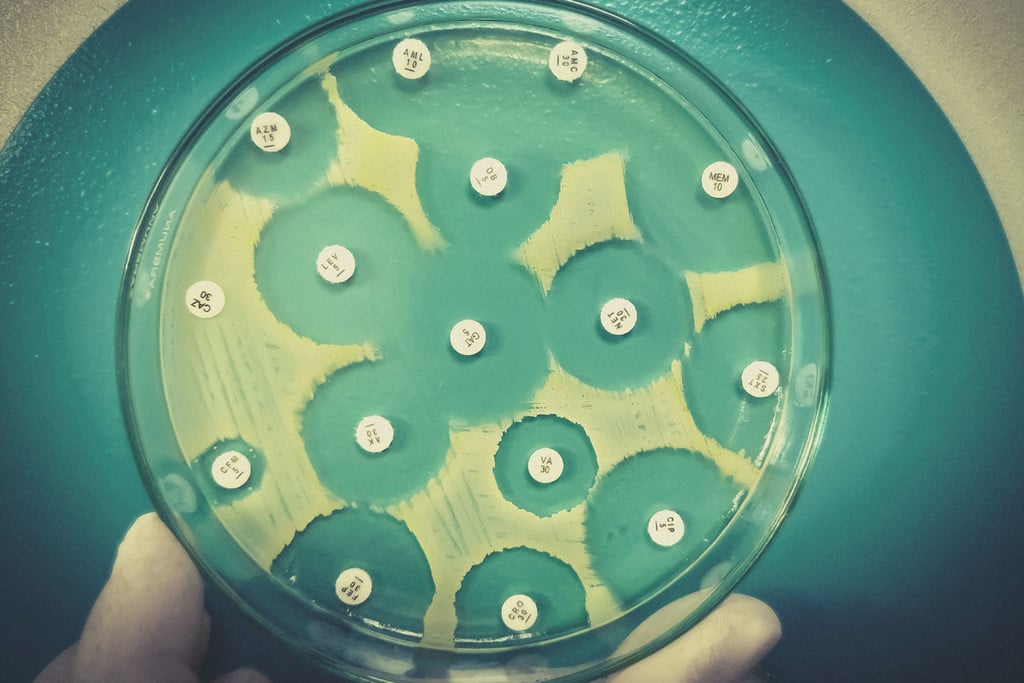
Darf man Gras rauchen, während man Antibiotika einnimmt?

.
Darf man Gras rauchen, während man Antibiotika einnimmt?
Darf man Cannabis rauchen, während man Antibiotika einnimmt? Wirkt es selbst als Antibiotikum? Begleite uns, während wir tief in Geschichte und Arten von Antibiotika eintauchen und klären, ob Cannabinoide wie THC und CBD mit ihnen interagieren bzw. ob Cannabis zukünftig einen Platz der Behandlung von Antibiotika-resistenten Bakterienstämmen hat.
Inhaltsverzeichnis:
- Die Beziehung zwischen Marihuana und Antibiotika: Zwei Ansätze
- Die Bedeutung von Antibiotika
- Die unterschiedlichen Arten von Antibiotika
- Darf man Weed rauchen, wenn man auf Antibiotika ist?
- Was ist eine Antibiotikaresistenz?
- Ist Marihuana ein potenzielles Antibiotikum?
- Was ist mit anderen antibakteriellen Cannabinoiden?
- Die Zukunft für Cannabis als ein Antibiotikum
Darf man Weed rauchen, während man Antibiotika einnimmt? Wenn man bedenkt, dass Millionen von Menschen täglich Cannabis konsumieren und ebenfalls täglich auch Millionen von Dosen Antibiotika eingenommen werden, ist es wichtig zu wissen, ob eine Wechselwirkung zwischen beidem besteht.
Die Beziehung zwischen Cannabis und Antibiotika kann jedoch tiefer als einfache Wechselwirkungen mit Medikamenten gehen.
Vorläufige Studien untersuchen das antibiotische Potenzial von Cannabisverbindungen in der Hoffnung, neue Waffen gegen arzneimittelresistente Bakterienstämme zu finden.
Im Folgenden erfährst Du, ob es sicher ist, Gras zu rauchen, während man Antibiotika einnimmt. Dann werden wir uns mit dem antibakteriellen Potenzial von Cannabisverbindungen befassen, um zu sehen, ob die Pflanze einen Platz in der Zukunft der Antibiotikamedizin einnehmen könnte.
Die Beziehung zwischen Marihuana und Antibiotika: Zwei Ansätze
Zunächst einmal sollten Cannabisnutzer wissen, ob sie ihre Gesundheit aufs Spiel setzen, falls sie Cannabis nutzen und gleichzeitig verschreibungspflichtige Antibiotika einnehmen. Schließlich interagiert Cannabis negativ mit einigen Medikamenten.
Cannabis darüber hinaus selbst ein interessantes Ziel bei der Suche nach Antibiotika-artigen Substanzen sein, die in der Lage sind, arzneimittelresistente Bakterienstämme zu bekämpfen.
Besinne Dich für einen Moment darauf, wie viel Glück wir in der heutigen Zeit haben. Sicher, viele von uns leiden unter dem Stress von Terminen, Rechnungen und Reizüberflutung. Aber wir halten es oft für selbstverständlich, dass die Menschen den Kampf mit Krallen und Zähnen, den unsere Vorfahren ertragen mussten, hinter sich gelassen haben. Die Natur ist ein Kreislauf aus Leben und Tod, ein ständiger Krieg zwischen unzähligen Arten. Einer unserer ältesten Feinde – die Bakterien – hätten uns in der Vergangenheit den Garaus machen können, aber heute haben wir das Glück, dass wir Zugang zu Pillen haben, die sie abtöten.
Antibiotika retten allein in den Vereinigten Staaten jedes Jahr über 200.000 Menschenleben. Aber der Mensch ist nicht die einzige Spezies, die dazu neigt, sich anzupassen und Dinge zu bewältigen, denn auch Bakterienarten mutieren und entwickeln Resistenzen. Jetzt suchen Forscher nach neuen Quellen für Antibiotika, um dieser Bedrohung zu begegnen – einige haben hinsichtlich dessen Cannabis im Visier.
Die Bedeutung von Antibiotika
Antibiotika sind eine unerlässliche Waffe im jahrhundertealten Krieg gegen mikrobielles Leben. Natürlich sind nicht alle mikroskopischen Organismen krankheitsverursachend: Der menschliche Darm enthält Billionen von Bakterien, Pilzen und Viren, die uns bei der Verdauung der Nahrung helfen und unser Immunsystem stärken. Aber viele andere Arten von Mikroben arbeiten nicht in solch einer symbiotischen Weise mit dem menschlichen Körper zusammen.
Es gibt unzählige Arten und Stämme von infektiösen Bakterien. Diese Organismen können auf verschiedene Weise in den menschlichen Körper gelangen, beispielsweise durch Kontakt, über die Luft oder durch Tröpfchen. Zum Beispiel dient der Verzehr eines schlecht zubereiteten Lebensmittels oft als Eintrittspforte für einige Arten.
Infektionen können jedoch an jeder Stelle des Körpers auftreten. Die Symptome entstehen entweder durch die Bakterien selbst oder durch die Reaktion des Körpers auf ihre Anwesenheit. Bakterien unterscheiden sich in ihrer Pathogenität (ihrem Potenzial, Krankheiten zu verursachen). Nur ein kleiner Prozentsatz der Arten verursacht beim Menschen Infektionen und Krankheiten, aber viele von ihnen können schwere Schäden verursachen.
Jedes Organ im menschlichen Körper ist anfällig für bakterielle Infektionen. Arten, die die Hirnhäute (Membranen, die das Gehirn und das Rückenmark schützen) angreifen, können Meningitis verursachen. Bakterien, die die Lunge befallen, können eine Lungenentzündung verursachen. Staphylococcus aureus, der normalerweise die Haut besiedelt, kann über Wunden in den Körper eindringen und die Herzklappen und das Abdomen infizieren.


Eine kurze Geschichte der Antibiotika
Zum Glück haben Antibiotika dazu beigetragen, ehemals tödliche Infektionen in kleinere Unannehmlichkeiten zu verwandeln. Infektionskrankheiten standen während des größten Teils der menschlichen Existenz an erster Stelle der Todesursachen. Die Entwicklung von Antibiotika hat uns eine wirksame Waffe gegen diesen unsichtbaren Feind beschert.
Es gibt Hinweise darauf, dass sich die Menschen die Kraft der Antibiotika seit Jahrtausenden zunutze gemacht haben. So sind beispielsweise Spuren des Antibiotikums Tetracyclin in menschlichen Skelettresten[1] aus dem alten sudanesischen Nubien aus der Zeit zwischen 350 und 550 n.u.Z. nachweisbar.
Die meisten von uns verbinden jedoch das Aufkommen lebensrettender Antibiotika mit Alexander Fleming und dem Beginn des "Zeitalters der Antibiotika". Fleming entdeckte das Antibiotikum Penicillin, als er Staphylococcus-Bakterien untersuchte. Nachdem er eine mit den Bakterien gefüllte Petrischale neben einem offenen Fenster abgestellt hatte, kehrte er zurück und fand die Schale mit Schimmelpilzen verunreinigt. Der neu hinzugekommene Pilz hatte jedoch auch die infektiösen Bakterien erfolgreich abgetötet.
Diese bahnbrechende Entdeckung wurde am 3. September 1928 gemacht und rettete schätzungsweise 200 Millionen Menschenleben[2].
-
Wie Antibiotika wirken
Antibiotika wirken in erster Linie auf zwei Arten. Sie verlangsamen entweder die Zellaktivität (bakteriostatisch) oder töten sie ab (bakterizid). Bakteriostatische Antibiotika verlangsamen die Zellaktivität der Bakterien, führen aber nicht zu deren völligem Absterben. Im Wesentlichen pausieren sie ihre Vermehrungsfähigkeit, so dass das Immunsystem ausreichend Gelegenheit hat, die aktuelle Infektion auszumerzen. Diese Medikamente erreichen dies durch Eingriffe in die DNA-Replikation, den Stoffwechsel und die Proteinproduktion.
Im Gegensatz dazu töten bakterizide Antibiotika Bakterien direkt ab. Sie hindern die Bakterien daran, eine Zellwand zu bilden, was zu ihrem schnellen Tod führt. Penicillin-Antibiotika sind bakterizid, darunter Penicillin V bei Halsentzündungen und Amoxicillin bei Brustinfektionen.
Antibiotika unterscheiden sich auch hinsichtlich der Bakterienarten, gegen die sie wirken. Einige werden als "Breitspektrum" eingestuft und greifen zahlreiche Arten an, darunter auch nützliche Bakterien, die sich im Darm befinden. Dies kann zu einem Ungleichgewicht im Mikrobiom und möglichen Verdauungsproblemen führen. Im Gegensatz dazu sind "Schmalspur"-Antibiotika selektiver in Bezug auf die Arten, die sie schädigen. Sie wirken sich nur auf 1–2 Bakterienarten aus und lassen viele unserer körpereigenen Mikroben in Ruhe leben.


-
Grampositive im Vergleich zu gramnegativen Bakterien
Einige Bakterien sind resistenter gegen Antibiotika und die von unserem Immunsystem gebildeten Antikörper als andere. Bakterien lassen sich in zwei Kategorien einteilen: grampositive und gramnegative. Dieser Name leitet sich von einer Technik namens Gram-Färbung ab, die zur Identifizierung von Bakterienarten verwendet wird.
Diese beiden Arten unterscheiden sich durch ihre Zellwände. Grampositive Bakterien haben keine äußere Membran, eine komplexe Zellwand und eine dicke Peptidoglykan-Schicht (Proteine und Kohlenhydrate). Gramnegative Bakterien hingegen besitzen eine äußere Lipidmembran und eine dünne Peptidoglykan-Schicht. Da gramnegative Arten eine dickere äußere Schicht haben, sind sie oft unempfindlicher gegenüber Antibiotika.
Obwohl der Begriff "Antibiotika" wörtlich "gegen das Leben" bedeutet, wirken diese Medikamente nur gegen eine bestimmte Kategorie von Mikroben, nämlich Bakterien. Antibiotika können den Körper aus mehreren Gründen nicht vor Viren schützen. Erstens dringen Viren in Wirtszellen ein, um sich zu vermehren, und bakteriostatische Antibiotika greifen keine Wirtszellen an. Zweitens besitzen Viren keine Zellwände, was bedeutet, dass bakterizide Antibiotika nichts zum Angreifen haben.
Die unterschiedlichen Arten von Antibiotika
Es gibt etliche unterschiedliche Arten von Antibiotika. Jede hilft, unterschiedliche Formen von bakteriellen Infektionen zu bekämpfen. Obwohl Hunderte von Antibiotika existieren, fallen die meisten von ihnen in die folgenden sechs Hauptgruppen:
| Penicilline | Diese Gruppe umfasst Penicillin, Amoxicillin, Flucloxacillin und weitere Medikamente. Penicilline helfen, Bakterien abzuwehren, indem sie sie daran hindern, schützende Zellwände zu bilden – Strukturen, die diese einzelligen Organismen zusammenhalten. Diese Medikamente werden zur Behandlung einer Vielzahl von Infektionen eingesetzt, einschließlich Infektionen der Haut, des Brustkorbs und der Harnwege. |
| Cephalosporine | Diese Breitbandantibiotika werden zur Bekämpfung zahlreicher Arten von Infektionen eingesetzt, einschließlich schwerwiegender Erkrankungen wie Meningitis, Lungenentzündung und Blutvergiftung. |
| Aminoglykoside | Diese Klasse von Antibiotika wird rekrutiert, um bestimmte Arten von gramnegativen Bakterien abzuwehren. Manchmal werden sie zusammen mit anderen Formen von Antibiotika eingesetzt und wegen des Risikos schwerwiegender Nebenwirkungen wie Nierenschäden meist in Krankenhäusern verabreicht. |
| Tetracycline | Zu dieser Gruppe gehörende Antibiotika, darunter Doxycyclin, töten Bakterien ab, indem sie die Proteinsynthese stören. Obwohl ihre Wirksamkeit aufgrund bakterieller Resistenzen etwas nachgelassen hat, werden sie weiterhin bei Erkrankungen wie Akne eingesetzt. |
| Makrolide | Diese Antibiotika werden Patienten verabreicht, die auf Penicillin allergisch reagieren. Makrolide sind auch wirksam bei der Bekämpfung von Lungeninfektionen, wie etwa einer Lungenentzündung. |
| Fluorchinolone | Medikamente dieser Klasse, wie etwa Ciprofloxacin, werden heutzutage aufgrund von Nebenwirkungen wie Übelkeit, Erbrechen und Empfindlichkeit gegen Sonnenlicht selten verschrieben. Früher verschrieben Ärzte sie zur Abwehr von Atemwegs- und Harnwegsinfektionen. |
| Penicilline |
| Diese Gruppe umfasst Penicillin, Amoxicillin, Flucloxacillin und weitere Medikamente. Penicilline helfen, Bakterien abzuwehren, indem sie sie daran hindern, schützende Zellwände zu bilden – Strukturen, die diese einzelligen Organismen zusammenhalten. Diese Medikamente werden zur Behandlung einer Vielzahl von Infektionen eingesetzt, einschließlich Infektionen der Haut, des Brustkorbs und der Harnwege. |
| Cephalosporine |
| Diese Breitbandantibiotika werden zur Bekämpfung zahlreicher Arten von Infektionen eingesetzt, einschließlich schwerwiegender Erkrankungen wie Meningitis, Lungenentzündung und Blutvergiftung. |
| Aminoglykoside |
| Diese Klasse von Antibiotika wird rekrutiert, um bestimmte Arten von gramnegativen Bakterien abzuwehren. Manchmal werden sie zusammen mit anderen Formen von Antibiotika eingesetzt und wegen des Risikos schwerwiegender Nebenwirkungen wie Nierenschäden meist in Krankenhäusern verabreicht. |
| Tetracycline |
| Zu dieser Gruppe gehörende Antibiotika, darunter Doxycyclin, töten Bakterien ab, indem sie die Proteinsynthese stören. Obwohl ihre Wirksamkeit aufgrund bakterieller Resistenzen etwas nachgelassen hat, werden sie weiterhin bei Erkrankungen wie Akne eingesetzt. |
| Makrolide |
| Diese Antibiotika werden Patienten verabreicht, die auf Penicillin allergisch reagieren. Makrolide sind auch wirksam bei der Bekämpfung von Lungeninfektionen, wie etwa einer Lungenentzündung. |
| Fluorchinolone |
| Medikamente dieser Klasse, wie etwa Ciprofloxacin, werden heutzutage aufgrund von Nebenwirkungen wie Übelkeit, Erbrechen und Empfindlichkeit gegen Sonnenlicht selten verschrieben. Früher verschrieben Ärzte sie zur Abwehr von Atemwegs- und Harnwegsinfektionen. |
Darf man Weed rauchen, wenn man auf Antibiotika ist?
Wir alle wissen, dass man keinen Alkohol trinken sollte, wenn man Antibiotika nimmt, aber was ist mit dem Rauchen von Weed?
Cannabis hat sicherlich ein besseres Gesamtsicherheitsprofil als Alkohol, doch Verbindungen in der Pflanze können mit einer Reihe anderer Drogen interagieren.
Im Folgenden erfährst Du, wie Cannabis den Medikamentenstoffwechsel beeinflusst, und ob es ratsam ist, während der Einnahme von Antibiotika THC oder CBD zu konsumieren.
-
Cannabis interagiert mit anderen Drogen
Cannabis zu nutzen, macht nicht nur high. Cannabinoide wie THC und CBD können das Endocannabinoid-System im ganzen Körper beeinflussen, was zu komplexen und weitreichenden, biochemischen Kaskaden führt.
Dein Körper baut alles ab und verstoffwechselt alles, was Du zu Dir nimmst, einschließlich Cannabinoide. Als Entgiftungsorgan und Angelpunkt des Stoffwechsels spielt die Leber eine wichtige Rolle hierbei. Genauer gesagt ist die Familie der Cytochrom-P450-Enzyme verantwortlich für die Metabolisierung mehrerer Cannabinoide. Mitglieder dieser Enzymfamilie haben zudem die Aufgabe, etwa 90% der Arzneimittel[3] zu verstoffwechseln.
Aufgrund ihrer Wechselwirkungen mit diesen Enzymen hemmen Cannabinoide wie THC und CBD jedoch den Cytochrom-P450-Medikamentenstoffwechsel[4], was zu erheblichen Arzneimittelwechselwirkungen führen kann. So haben zum Beispiel bestimmte Berichte ergeben, dass Cannabis die gerinnungshemmende Wirkung des Medikaments Warfarin verstärken kann, indem es seine Verstoffwechslung durch diesen Wirkmechanismus unterbricht. Diese Enzyme sind ebenfalls verantwortlich für die Metabolisierung mehrerer Antibiotika, einschließlich Erythromycin, was die Möglichkeit von Nebenwirkungen eröffnet.
-
Interagiert THC mit Antibiotika?
Studien zu Wechselwirkungen zwischen THC und Antibiotika ist nach wie vor rar gesät. Obwohl THC und einige Antibiotika jeweils dieselben wichtigen Leberenzyme beeinflussen, scheint das Risiko ernsthafter Wechselwirkungen relativ gering zu sein, doch dies ist bisher nur anekdotische Evidenz. In der Tat haben keine eingehenden Studien das Risiko analysiert, aber es gibt einige Berichte, die unerwünschte Ereignisse bei Personen dokumentieren, die beide Substanzen gleichzeitig einnehmen.
Vor diesem Hintergrund könnte THC durch die Veränderung des Leberstoffwechsels die Wahrscheinlichkeit erhöhen, die Nebenwirkungen von Antibiotika zu erleben. Darüber hinaus hat das Rauchen irgendwelcher Substanzen während einer Atemwegsinfektion das Potenzial, die Schwere der Erkrankung zu erhöhen.[5]
Außerdem deuten einige Hinweise darauf hin, dass THC ein Immunsuppressivum[6] ist. Wir empfehlen dringend, Deinen Arzt über Deine Cannabisnutzung zu informieren, falls Du vorhast, das Kraut während der Einnahme von Antibiotika zu nutzen.
-
Interagiert CBD mit Antibiotika?
CBD wirkt als starker Inhibitor von Cytochrom-P450-Enzymen und kann daher den Metabolismus bestimmter Antibiotika verändern und Patienten für unerwünschte Ereignisse und ein erhöhtes Risiko von Nebenwirkungen prädisponieren.
Wie bei THC auch, gibt es wenig bis gar keine Forschung, die das Risikoniveau bei der gleichzeitigen Einnahme dieser Substanzen beschreibt. Sowohl CBD als auch Antibiotika werden jedoch jeden Tag von Millionen von Menschen getrennt eingenommen. Die Menschen mischen beides wahrscheinlich oft, wobei allerdings keine größere Anzahl von detaillierten Berichten über schwerwiegende unerwünschte Ereignisse vorliegen. Das soll aber nicht heißen, dass sie nicht auftreten können. Falls Du ein Antibiotika-Rezept erhältst, solltest Du Deinen Arzt über Deine CBD-Nutzung informieren und seinen Ratschlägen folgen.


-
Ist Cannabis die Lösung für antibiotikaresistente Bakterien?
Die Wissenschaft muss die Auswirkungen der gleichzeitigen Einnahme von Cannabis und Antibiotika erst noch vollständig aufklären. Interessanterweise versuchen einige Forscher allerdings festzustellen, ob Cannabisverbindungen selbst antibiotisch sind. Während sich antibiotikaresistente Bakterienstämme weiterentwickeln und konventionellen Medikamentenoptionen trotzen, testen Wissenschaftler Verbindungen wie THC und CBD auf dem mikrobiellen Schlachtfeld. Eine in der Zeitschrift Communications Biology veröffentlichte Studie[7] befasste sich beispielsweise mit der Verabreichung von CBD gegen den "äußerst bedrohlichen" Erreger Neisseria gonorrhoeae, um festzustellen, ob das Cannabinoid therapeutisches Potenzial bietet.
Was ist eine Antibiotikaresistenz?
Antibiotika haben Millionen von Leben gerettet und tun dies auch weiterhin. Aber Bakterien weigern sich, wie leichte Beute still abzuwarten. Wie alle anderen Lebensformen auf der Erde besitzen sie die Fähigkeit, sich an Bedrohungen anzupassen, Herausforderungen zu meistern und ihr eigenes Überleben zu sichern. Diese Eigenschaft hat es einigen Arten ermöglicht, eine Resistenz gegen Antibiotika zu entwickeln. Die Ursache für dieses Problem liegt an etwas, das die Entwicklung allen Lebens steuert: die natürliche Auslese.
Genau wie andere Organismen entwickeln auch einzelne Bakterien zufällige Mutationen. Einige dieser Mutationen sind funktionell, während andere völlig nutzlos sind. Hin und wieder kommt es jedoch zu einer Mutation, die die Anpassungs- und Überlebensfähigkeit eines Organismus verbessert. Einige Bakterien entwickeln Mutationen, die sie widerstandsfähiger gegen Antibiotika machen als andere. Während die Bakterien, die für Antibiotika empfindlich sind, absterben, erhalten diejenigen, die die vorteilhafte Mutation besitzen, mehr Ressourcen und vermehren sich.
Ein Beispiel für diese erfolgreichen Mutationen ist die Entwicklung von Staphylococcus aureus zu MRSA (Methicillin-resistenter Staphylococcus aureus). Diese Bakterienform hat eine Resistenz gegen Methicillin und Penicillin entwickelt und schafft es dank einer genetischen Anpassung, ihre Zellwand gegenüber diesen Antibiotika weiter aufzubauen.
-
Die drohende Gefahr von Antibiotikaresistenzen
Die Weltgesundheitsorganisation (WHO) betrachtet die Antibiotikaresistenz als eine der größten Bedrohungen für die globale Gesundheit und Entwicklung. Obwohl sich Antibiotikaresistenzen auf natürliche Weise entwickeln, weist die WHO auf den Missbrauch von Antibiotika bei Mensch und Tier als einen Faktor hin, der diesen Prozess begünstigt. Infolgedessen sind Infektionen wie Lungenentzündung, Tuberkulose, Gonorrhö und Salmonellose immer schwieriger zu behandeln.
Jeder Einzelne kann dazu beitragen, dieses Phänomen einzudämmen, indem er nur Antibiotika einnimmt, die ihm vom Arzt verschrieben wurden, und indem er sie nicht einnimmt, wenn er sie nicht braucht. Auch die Angehörigen der Gesundheitsberufe können zur Verlangsamung der Antibiotikaresistenz beitragen, indem sie diese Medikamente nicht übermäßig verschreiben.
Auch Forscher tragen ihren Teil dazu bei, indem sie nach neuen Formen von Antibiotika suchen, die mutierte Stämme bekämpfen können. Aber wo suchen sie? Einige haben Cannabis als potenzielle Quelle für neue Antibiotika im Auge.


Ist Marihuana ein potenzielles Antibiotikum?
Wie kann eine natürliche Pflanze mutierende Bakterien in ihrem Lauf aufhalten? Nun, erstens stammen Antibiotika von Pilzen ab und somit von einer Gruppe natürlich vorkommender Organismen. Zweitens haben sich Pflanzen über Millionen von Jahren ein evolutionäres Wettrüsten mit Bakterien und anderen Mikroben geliefert. Sie sind ziemlich effizient darin geworden, Moleküle zu produzieren, die diese Krankheitserreger in Schach halten.
Genauer gesagt schützen sich die Pflanzen weitgehend durch die Herstellung von Sekundärmetaboliten. Diese Moleküle sind nicht am Wachstum oder an der Entwicklung der Pflanze beteiligt, sondern dienen vielmehr als chemische Waffen. Und Cannabispflanzen besitzen ein ganzes Arsenal davon: Sie produzieren zu diesem Zweck über 100 Cannabinoide und 200 Terpene.
-
Das antibiotische Potenzial von Cannabinoiden und Terpenen
Forscher haben die antibakteriellen Eigenschaften von Cannabisextrakten und Cannabinoiden seit mehreren Jahrzehnten erforscht. Die ersten Studien fanden in den 1950er Jahren statt. Obwohl die Forscher bakterientötende Wirkungen beobachteten, konnten sie aufgrund mangelnder Kenntnisse über die Phytochemie von Cannabis damals die aktiven Bestandteile nicht bestimmen.
Ein Durchbruch gelang den Forschern jedoch 1976, als sie die bakteriostatische und bakterientötende Wirkung von THC und CBD gegen grampositive Bakterien entdeckten. In Studien wurden auch ätherische Öle aus Hanf gegen einige Formen von Bakterien getestet.
Diese Präparate enthalten neue Cannabinoide und Terpene wie Pinen, Limonen und Ocimen. In den Studien wurde in vitro eine mäßige bis gute antimikrobielle Aktivität festgestellt, was darauf hindeutet, dass sich eine Kombination von Cannabisbestandteilen in der künftigen Forschung am Menschen als nützlich erweisen könnte.
Bei der Suche nach neuartigen Antibiotika haben sich die Studien auf mehrere verschiedene Cannabinoide konzentriert. THC, die wichtigste psychotrope Komponente von Cannabis, die das "High" verursacht, scheint vielversprechend zu sein. In Studien wird seine Wirksamkeit endlich eingehender untersucht und die Ergebnisse einer Studie aus dem Jahr 2008 rechtfertigen eine weitere Erforschung[8] seiner Wirkung gegen MRSA.
Was ist mit anderen antibakteriellen Cannabinoiden?
THC steht in der Cannabisforschung oft im Mittelpunkt des Interesses. Natürlich ist sein psychotroper Status immer ein heißes Diskussionsthema. Während einige Konsumenten diese Wirkungen zu schätzen wissen, sind nicht-psychotrope Cannabinoide für Forscher attraktiver, da sie die Patienten nicht solchen Nebenwirkungen aussetzen.
| CBD | |||||||
|---|---|---|---|---|---|---|---|
|
CBD, oder Cannabidiol, erzeugt keinen Rausch. Stattdessen berichten die Anwender von einer Wirkung mit klarem Verstand, die die kognitiven Funktionen nicht beeinträchtigt. CBD steht im Mittelpunkt von Hunderten von Studien, in denen sein möglicher Nutzen untersucht wird, einschließlich seiner Wirkung gegen antibiotikaresistente Bakterien. Ein Paper aus dem Jahr 2021 mit dem Titel "Das antimikrobielle Potenzial von Cannabidiol" wies auf einige ernsthafte Fortschritte in diesem Bereich hin[9]. Die Daten dokumentieren das Potenzial von CBD, gramnegative Bakterien wie Neisseria gonorrhoeae, von denen eine "akute Gefahr" ausgeht, zu bekämpfen. |
|||||||
| CBG | |||||||
| Hast Du jemals von Cannabigerol, auch CBG genannt, gehört? Seine saure Form, CBGA, ist als das "Mutter-Cannabinoid" bekannt. Dieses nicht psychotrope Molekül dient als chemischer Vorläufer für andere Cannabinoide, einschließlich THC und CBD. Forscher haben CBG auch auf sein antibiotisches Potenzial hin untersucht. In Studien wurde es in Tierversuchen mit MRSA-infizierten Mäusen mit Vancomycin verglichen – einem Medikament, das zur Behandlung zahlreicher Arten von bakteriellen Infektionen eingesetzt wird. | |||||||
| CBD | |||||||
|---|---|---|---|---|---|---|---|
|
CBD, oder Cannabidiol, erzeugt keinen Rausch. Stattdessen berichten die Anwender von einer Wirkung mit klarem Verstand, die die kognitiven Funktionen nicht beeinträchtigt. CBD steht im Mittelpunkt von Hunderten von Studien, in denen sein möglicher Nutzen untersucht wird, einschließlich seiner Wirkung gegen antibiotikaresistente Bakterien. Ein Paper aus dem Jahr 2021 mit dem Titel "Das antimikrobielle Potenzial von Cannabidiol" wies auf einige ernsthafte Fortschritte in diesem Bereich hin[9]. Die Daten dokumentieren das Potenzial von CBD, gramnegative Bakterien wie Neisseria gonorrhoeae, von denen eine "akute Gefahr" ausgeht, zu bekämpfen. |
|||||||
| CBG | |||||||
| Hast Du jemals von Cannabigerol, auch CBG genannt, gehört? Seine saure Form, CBGA, ist als das "Mutter-Cannabinoid" bekannt. Dieses nicht psychotrope Molekül dient als chemischer Vorläufer für andere Cannabinoide, einschließlich THC und CBD. Forscher haben CBG auch auf sein antibiotisches Potenzial hin untersucht. In Studien wurde es in Tierversuchen mit MRSA-infizierten Mäusen mit Vancomycin verglichen – einem Medikament, das zur Behandlung zahlreicher Arten von bakteriellen Infektionen eingesetzt wird. | |||||||
Die Zukunft für Cannabis als ein Antibiotikum
Können wir also damit rechnen, hinter Apothekentheken bald Antibiotika auf Cannabisbasis zu sehen? Noch nicht. Forscher haben Cannabinoide gegen besorgniserregende Bakterienstämme getestet, doch die Studien sind noch präklinisch.
Während die Wissenschaft weiterhin THC, CBD und andere Verbindungen gegen Petrischalen-Pathogene einsetzt, hoffen wir, auch mehr Studien im Bereich der Arzneimittelwechselwirkungen zwischen Cannabis und Antibiotika zu sehen. Neue Erkenntnisse in diesem Bereich werden Patienten und Ärzten gleichermaßen dabei helfen einzuschätzen, ob sie die Cannabisnutzung bei der Behandlung von Infektionen mit Antibiotika fortsetzen oder einstellen sollten.
Medizinischer HaftungsausschlussInformationen, die auf dieser Webseite aufgeführt sind und auf die verwiesen oder verlinkt wird, dienen nur allgemeinen Aufklärungszwecken und bieten keine professionelle medizinische oder rechtliche Beratung. Royal Queen Seeds weder billigen, befürworten noch fördern legalen oder illegalen Drogenkonsum.
Royal Queen Seeds kann nicht für Material von Referenzen auf unseren Seiten oder auf Seiten verantwortlich gemacht werden, zu denen wir Links bereitstellen, die legalen oder illegalen Drogengebrauch oder illegale Aktivitäten billigen, befürworten oder fördern.
Bitte konsultiere Deinen Arzt, bevor Du irgendwelche Produkte/Methoden ver-/anwendest, auf die auf dieser Webseite verwiesen oder verlinkt wird.
- A Brief History of the Antibiotic Era: Lessons Learned and Challenges for the Future https://www.ncbi.nlm.nih.gov
- One discovery that changed the world | Florey 120 Anniversary | University of Adelaide https://health.adelaide.edu.au
- The Effect of Cytochrome P450 Metabolism on Drug Response, Interactions, and Adverse Effects https://www.aafp.org
- Cannabinoid Interactions with Cytochrome P450 Drug Metabolism https://pubmed.ncbi.nlm.nih.gov
- Smoking in acute respiratory infections https://www.cebm.net
- How cannabis suppresses immune functions https://www.sciencedaily.com
- The antimicrobial potential of cannabidiol https://www.nature.com
- Antibacterial cannabinoids from Cannabis sativa: a structure-activity study - PubMed https://pubmed.ncbi.nlm.nih.gov
- The antimicrobial potential of cannabidiol | Communications Biology https://www.nature.com
